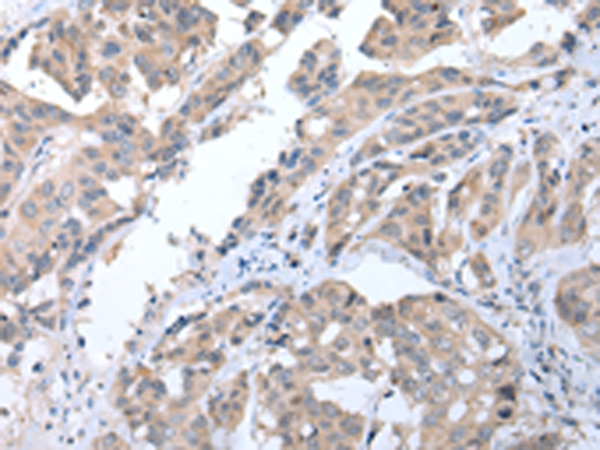

中文名稱(chēng):兔抗ALDH2多克隆抗體
英文名稱(chēng): Anti-ALDH2 rabbit polyclonal antibody
別 名: ALDM; ALDHI; ALDH-E2
抗 原: ALDH2
儲(chǔ) 存: 冷凍(-20℃)
宿 主: Rabbit
反應(yīng)種屬: Human, Mouse, Rat
相關(guān)類(lèi)別: 一抗
標(biāo) 記 物: Unconjugate
克隆類(lèi)型: rabbit polyclonal
技術(shù)規(guī)格
|
Background: |
This protein belongs to the aldehyde dehydrogenase family of proteins. Aldehyde dehydrogenase is the second enzyme of the major oxidative pathway of alcohol metabolism. Two major liver isoforms of aldehyde dehydrogenase, cytosolic and mitochondrial, can be distinguished by their electrophoretic mobilities, kinetic properties, and subcellular localizations. Most Caucasians have two major isozymes, while approximately 50% of Orientals have the cytosolic isozyme but not the mitochondrial isozyme. |
|
Applications: |
ELISA, WB, IHC |
|
Name of antibody: |
ALDH2 |
|
Immunogen: |
Synthetic peptide of human ALDH2 |
|
Full name: |
aldehyde dehydrogenase 2 family (mitochondrial) |
|
Synonyms: |
ALDM; ALDHI; ALDH-E2 |
|
SwissProt: |
P05091 |
|
ELISA Recommended dilution: |
2000-5000 |
|
IHC positive control: |
Human breast cancer |
|
IHC Recommend dilution: |
20-100 |
|
WB Predicted band size: |
56 kDa |
|
WB Positive control: |
Human lung cancer tissue |
|
WB Recommended dilution: |
500-2000 |

購(gòu)物車(chē)
購(gòu)物車(chē) 幫助
幫助
 021-54845833/15800441009
021-54845833/15800441009
